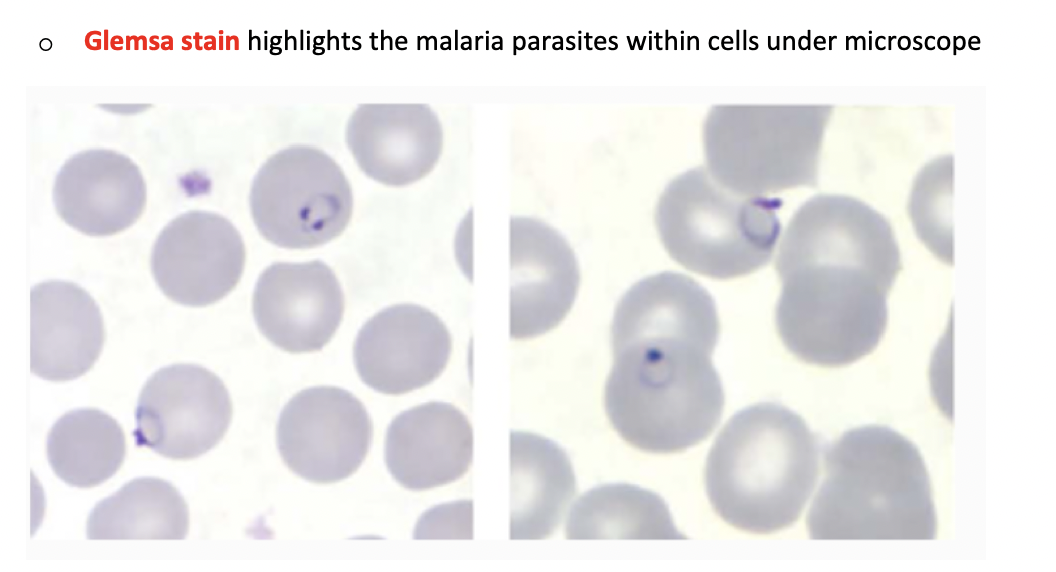

what are Protozoa?
single celed eukarytpic organsism
transmitted by
vector-borne
faecal oral
sexuallty transmitted
what protzoan parasite causes Malaria
Plasmodium species
vectro borne protzoan parasite
what vector transmits malaria (plasmodium species)
the bite of the femal anopheles mosquito
can alos occur due to blood transufsion and vertically
what is the most common plasmoidum speciies which causes malaria?
Plasmoidum falciparum- is the most common- 75%
plasmoidum vivax
plasmodium ovale
plamsodim malarie
plasmodium Knowlesi
describe the Mosquito phase of the malrai lifesycle
describe the exo-erythrocytic cyle of malaria
what is the name of malaria parasite stage that infects red bklood cells
Erthyrocitic cycke
meroziotes infect red bllood cells
form ring stage Trophoziotes that mature into schizonts-
svhizonts butrs to release more meroziotes, lysis of RBC
this lysis of RBC causes cylcicnal symptoms/fever
when do some parasites differentiat into sexual gametocytes?
in teh ertythocyte stafes
gametocytes are ingested by anopheles mosquitop during blood meal int he mosquit they replicate and make there wya into mosquito slaivary glands - inoculatre new human host during bone meal
give a quick name summary of the satges of malaria parasite lifw
sporozoites (infect travel to liver)
schizonts (in liver xells)
(can becoem hypoziotes P.vivax, P.ovale)
burst release Meroziotes
infect RBC-form ringstage trophoziotes
mature in schizonts- rputur- meroziotes again
gaemetocuytes

what is the cause of temperatutre/ symtpoms cyclical appearance
depending on species can see regular/irregular cycles of fever-
this depends on when teh parasitic schizont cells ruputre and spread merozoites- Aexaul replication. when. rupture release TNF-a and other inflaamtory markers
in P.flaciuparum- this occurs every 48 hours , but can vary alot

why does plasmodium falicparum cause a more severe disease in relation to the spleen
causes blocage of cappilarires in the spleen and reuslts in spleen dysfunction- unabel tro remove damaged RBC and thos infected with malaria parasites
what are the clinical features of uncomplicated malaria?
appear 10-15 days after infectiv mosquito bite
early symtpoms mil/non-sopcpefic ferv, headahces chills
uncomplciated= limtied to milder symptoms
describe the clinical symptoms of those with complicated malaria
life threatening
high fever
severe anaemai
kidney failure
jaudince
cerebral malria
convulsiosn
respriaotry distress
who is most at risk of complciated malaria
children under 5, pregnant women, people with HIV/AIDS- higher risk of contracting malaria and having severe disease
Describe the classical malaria presentation
Parooxysm- attack of disaes associated with schizont ruputure follows 3 phases
cold stage- cold shivers
hot stage (feels hot, flsuehd, dry skin, measurabel fever)
sweating /fever breaking stage ( fevr drops and the patient sweats)

how is malaria diagnosed
thick film- identidy the presence of malaria
thin film- identidfy species of malaria and quanityf the parasitaemia.
using thin film alone has limited snesicity for malaira- which is why we use both
then use Glemsa stain
what features on blood film, other blood tests and clinical features would indicate sevre Malaria
describe malaria prevention methods
preventable and treatment nets
contorl vector- indoor resiudl spraying insecticide ,on walsla dn ceilignw ehre anophelees like to land
people living endmeci area- partial immunity to malaria follwoing repeat infeciton
sickle cell trait
travel advice to prevent Malaria ABCD
awareness of rrisk
bite prevention (sleep underinsectivide treated net, mosquito net)
chemoprophylazis- antimalarias
diagnosis- if dveloep fever of 38 or more within 1 wweek after being in malaria risk area, who devekopm symptoms or within 1 year of reutrn ahsoul seek emidate care
why is chlorquine now not used routinely as early prophylaxis?
wide spread reistance
now options include- doxycycline, Meflouquine, Malarone (atovaquone-proguanil)
how do we treat uncomplicated malaria?
what is ACT?
drug treatmemnt depends on area- resistance
avoid monotherpay contirbuiting t drug resistance
Artermisin combined therpay (ACT)= artesunate + mefloquine
what si severe/ complicated malaria
treat with IV artesunate
then follow by oral ACT
treat comoplicatios